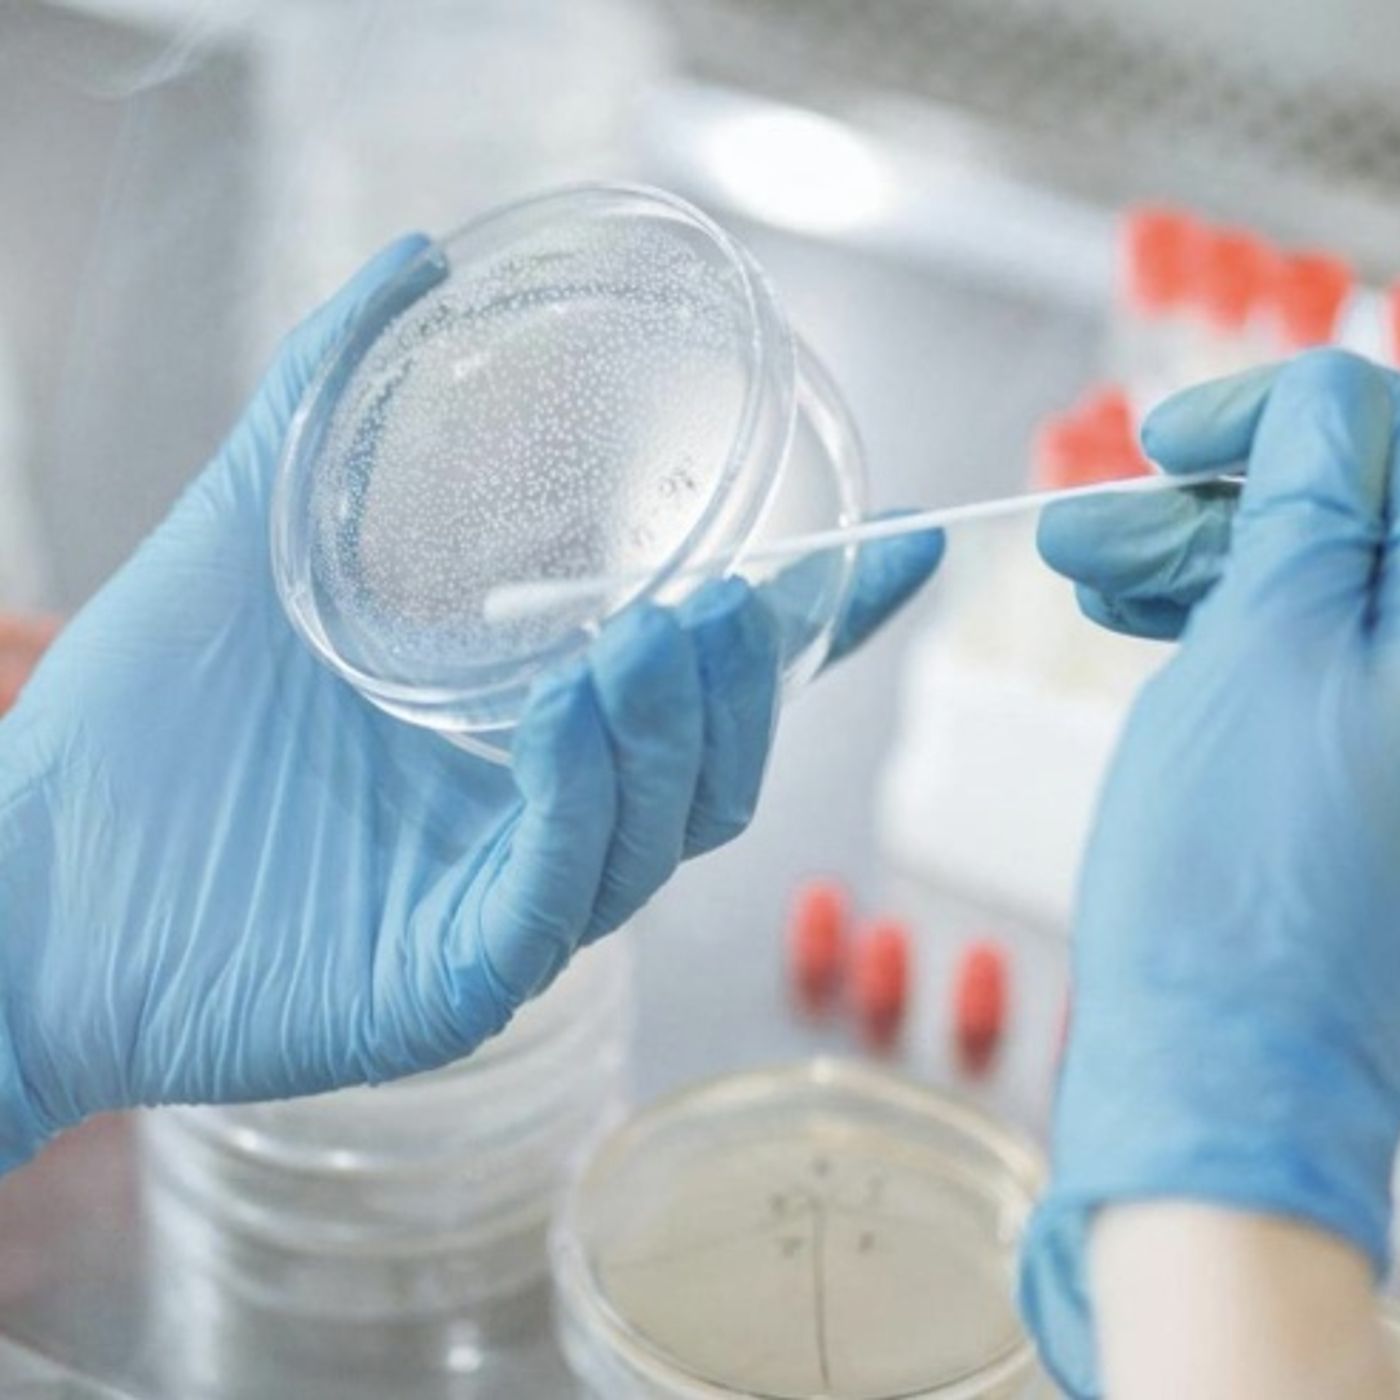
InfermieriAttivi

Shows

InfermieriAttiviSala operatoria: la temperatura bassa favorisce le infezioniLa sala operatoria è tradizionalmente un ambiente molto freddo. Per anni, la spiegazione standard è stata: "si è sempre fatto così per ridurre il rischio di infezioni".Tuttavia, ponendo la questione a un'Intelligenza Artificiale, la realtà che emerge è ben diversa, come anticipato nel titolo di questo articolo. In realtà, le basse temperature agiscono negativamente sui tessuti esposti. Per conservare il calore, l'organismo attiva la vasocostrizione periferica; questo riduce l'apporto di ossigeno ai tessuti, rendendoli paradossalmente più suscettibili alle infezioni del sito chirurgico. Se l'ipotermia intraoperatoria comporta numerosi svantaggi per il paziente, l'unico reale "beneficio" del freddo sembra essere il comfort termico del chiru...
2026-03-1306 min
InfermieriAttiviAnalisi della Legge 116/2021: Implicazioni cliniche, medico-legali e organizzative per i professionisti sanitari nella gestione dell'arrestoL’arresto cardiaco improvviso (OHCA - Out-of-Hospital Cardiac Arrest) rappresenta una delle principali emergenze sanitarie nei paesi industrializzati, configurandosi come una sfida complessa per i sistemi di emergenza-urgenza e per l'intera comunità civile. In Europa si stima che ogni anno oltre 400.000 persone siano colpite da arresto cardiaco, con tassi di sopravvivenza che, storicamente, faticano a superare la soglia del 10% in assenza di un intervento immediato.1 In Italia, i casi annui si attestano intorno ai 60.000, rendendo la gestione della "Catena della Sopravvivenza" una priorità di sanità pubblica.3 La Legge 4 agosto 2021, n. 116, intitolata "Disposizioni in materia di utilizzo dei defibrillatori semiautomatici e autom...
2026-03-1206 min
InfermieriAttiviInfermieri: tempo cambio divisa e CCNLIl tempo di vestizione è un tema estremamente specifico e dibattuto che tocca da vicino la quotidianità di ogni infermiere. Ho deciso di approfondire l'argomento attraverso una ricerca con Gemini Pro, convinto di trovare risposte immediate; tuttavia, ne è emerso un quadro normativo e giurisprudenziale di straordinaria complessità.Il rapporto di ricerca che segue mette in luce quanto le sentenze della Cassazione siano state determinanti per il riconoscimento di diritti che, in altri settori lavorativi, sono consolidati da tempo. Nonostante la tecnicità della materia, un dato emerge con prepotenza: la battaglia legale si sta spostando sul terreno della prescrizione, attualmente fissata a 5 a...
2026-03-1105 min
InfermieriAttiviDisamina critica e osservazionale del cateterismo vescicale, una tecnica non banaleIl cataterismo vescicale è una di quelle tecniche presente in ogni reparto e se non si tratta del posizionamento è la gestione che ci coinvolge come infermieri.La ricerca online con un IA può arrivare ad un elenco di raccomandazioni di linee guida dove Gemini fa un semplice copia incolla. Il tipo di articolo che voglio proporti è un'analisi anche degli aspetti anatomici, il risultato è stato superiore alle aspettative.Questo articolo è stato realizzato con un GEM (una personalizzazione di Gemini pro) dove gli ho chiesto di andare ad indagare nei contenuti online fisiopatologici, di avere un tono rigoroso e di non utilizzare nessun temini...
2026-03-0504 min
InfermieriAttiviL’Intelligenza Artificiale in sanità: tra algoritmi e umanità, intervista a Pietro GiurdanellaIn occasione del congresso FADOI-ANIMO tenutosi a Bologna il 13 febbraio, il mondo sanitario si è interrogato sulle sfide poste dalla transizione digitale.Tra i protagonisti del dibattito, il Dott. Pietro Giurdanella, Presidente dell’Ordine delle Professioni Infermieristiche (OPI) di Bologna e consigliere nazionale FNOPI con delega alla sanità digitale, ha offerto una visione lucida e pragmatica sul ruolo dell'Intelligenza Artificiale (IA) nel quotidiano dei professionisti emiliano-romagnoli.Per saperne di più leggi l'articolo completo su InfermieriAttivi: "L’Intelligenza Artificiale in sanità: tra algoritmi e umanità, intervista a Pietro Giurdanella".
2026-02-2808 min
InfermieriAttiviFADOI Emilia-Romagna: il passaggio di testimone tra Fabio Gilioli e Federico Lari al XXVII Congresso RegionaleIn occasione del 27° Congresso Regionale FADOI-ANÍMO Emilia-Romagna, tenutosi il 13 febbraio 2026, si è assistito a un momento simbolico e strategico per la medicina interna: il passaggio di consegne alla guida della società scientifica regionale.In un clima di forte coesione interprofessionale, l'evento ha esplorato le nuove frontiere tecnologiche, con un focus particolare sull'integrazione dell'Intelligenza Artificiale nei reparti e sulle sfide poste da una popolazione di pazienti sempre più complessa e fragile. Di seguito, la trascrizione dei momenti salienti del confronto con il Presidente uscente, il Dott. Fabio Gilioli, e il Presidente entrante, il Dott. Federico Lari.Per saperne di pi...
2026-02-1911 min
InfermieriAttiviSanità Digitale in Emilia-Romagna: i risultati della survey di Giacomo Testa sulle competenze di medici e infermieriIn occasione del 27° Congresso Regionale FADOI-ANÍMO Emilia-Romagna, svoltosi il 13 febbraio 2026, ho intervistato Giacomo Testa, infermiere presso la Medicina Interna dell'Azienda USL di Bologna.Al centro del colloquio, i risultati di un'importante indagine conoscitiva sulle competenze digitali di medici e infermieri e l'impatto delle nuove tecnologie, tra cui l'Intelligenza Artificiale, sulla pratica clinica e relazionale.Per saperne di più leggi l'articolo completo su InfermieriAttivi: "Sanità Digitale in Emilia-Romagna: i risultati della survey di Giacomo Testa sulle competenze di medici e infermieri".
2026-02-1810 min
InfermieriAttiviIntervista a Vanessa Mazzali in occasione del 27° Congresso Regionale FADOI-ANÍMOIn occasione del 27° Congresso Regionale FADOI-ANÍMO, svoltosi il 13 febbraio 2026, ho avuto il piacere di confrontarmi con Vanessa Mazzali su temi cruciali per il futuro della nostra professione in area medica.In questa intervista, Vanessa Mazzali delinea le priorità del suo nuovo mandato, sottolineando l’importanza di restituire dignità e attrattività a un contesto spesso faticoso, ma profondamente formativo. Dalla sinergia interdisciplinare con FADOI al riconoscimento della Medicina Interna come "specialità fondamentale", fino alla filosofia della Slow Medicine, emerge un ritratto dell'infermiere come perno insostituibile della cura.Per saperne di più leggi l'articolo completo su...
2026-02-1706 min
InfermieriAttiviStrategie di integrazione reddituale per il personale infermieristico del SSN: analisi normativa, fiscale e contrattuale (Anno 2026)La possibilità di guadagnare qualcosa in più è sempre molto allettante, ma è necessario sapere in quale ambiente normativo ci si muove altrimenti è possibile avere delle delusioni o incorrere in sanzioni pesanti.Nel precedente articolo sul costo orario di un turnista è stato riportato quanto spende l'azienda per un dipendente e lo stesso importo dovrebbe chiedere il libero professionista per non fare concorrenza sleale o per non regalare soldi al datore di lavoro. Il report fa degli esempi "esagerati" per rendere l'idea del confronto fra le possibilità che il CCNL offre.Per saperne di più leggi l'articolo completo su Infermie...
2026-02-0706 min
InfermieriAttiviTrattato sulle nuove patologie polmonari indotte da inalazione di aerosol (vaping) nella popolazione adolescenziale europea: analisi multidiIl panorama della salute pubblica europea sta attraversando una trasformazione radicale e preoccupante, caratterizzata dall'emergere e dalla rapida diffusione dei dispositivi elettronici di somministrazione della nicotina (ENDS), comunemente noti come sigarette elettroniche o "vapes".Sebbene inizialmente introdotti nel mercato globale come strumenti di riduzione del danno per fumatori adulti cronici, questi dispositivi hanno subito una metamorfosi funzionale e culturale, diventando il vettore primario di iniziazione alla dipendenza da nicotina per le nuove generazioni.Per saperne di più leggi l'articolo completo su InfermieriAttivi: "Trattato sulle nuove patologie polmonari indotte da inalazione di aerosol (vaping) nella popolazione adolescenziale e...
2026-02-0606 min
InfermieriAttiviGuida professionale alla consegna infermieristica: come scrivere in sicurezzaL'esercizio della professione infermieristica in Italia ha subito, nell'ultimo ventennio, una metamorfosi radicale, transitando da una dimensione meramente esecutiva, ancorata al mansionario, a una sfera di piena autonomia intellettuale e responsabilità professionale. Questo passaggio, sancito storicamente dall'abolizione del mansionario (Legge 42/1999) e consolidato dalla Legge 251/2000, trova la sua massima espressione normativa nella Legge 24/2017 (Legge Gelli-Bianco) e nei recenti aggiornamenti del Codice Deontologico della FNOPI (2019 e 2025).In questo scenario, la documentazione sanitaria e, nello specifico, il passaggio di consegne infermieristiche, cessa di essere un adempimento burocratico residuale per assurgere al rango di atto costitutivo del processo di cura e principale strumento d...
2026-02-0205 min
InfermieriAttivi2026 Analisi comparativa dei permessi per il diritto allo studio (150 ore) nei contratti collettivi nazionali di lavoro del settore socio-saIl diritto allo studio rappresenta un pilastro fondamentale dell'ordinamento giuridico italiano, trovando la sua legittimazione primaria negli articoli 3, 33 e 34 della Carta Costituzionale, i quali sanciscono il dovere della Repubblica di rimuovere gli ostacoli che impediscono il pieno sviluppo della persona umana e garantiscono l'accesso all'istruzione per i capaci e i meritevoli.1Per il professionista infermiere, l'esercizio di tale diritto non si configura esclusivamente come un'opportunità di accrescimento culturale individuale, ma assume una valenza strategica per l'intero sistema salute.Per saperne di più leggi l'articolo completo su InfermieriAttivi: "2026 Analisi comparativa dei permessi per il diritto allo studio (150 ore) nei...
2026-02-0104 min
InfermieriAttiviGestione clinica e assistenziale del paziente con sospetta meningite e sepsi meningococcica: protocolli, monitoraggio e nursing avanzatoLa meningite batterica acuta rappresenta una delle emergenze infettivologiche più complesse e tempo-dipendenti in medicina acuta. Per il professionista infermieristico, sia esso operante in Triage, in Pronto Soccorso o in un reparto di degenza, la capacità di intercettare precocemente i segnali clinici di deterioramento neurologico e settico costituisce il fattore discriminante per la sopravvivenza del paziente.Questo trattato si propone di analizzare in profondità il ruolo dell'infermiere nella gestione della meningite, spaziando dalla fisiopatologia applicata alla semiotica clinica, dalla gestione procedurale della rachicentesi alla somministrazione critica della terapia antibiotica, fino agli aspetti medico-legali e di sanità pubblica.Per...
2026-01-3105 min
InfermieriAttiviLa gestione dell'accesso venoso periferico, le raccomandazioni dalle LGLe linee guida internazionali offrono raccomandazioni diversificate in base ai contesti clinici: dall'accesso venoso periferico a quello centrale, con protocolli specifici per popolazioni che vanno dall'adulto al paziente pediatrico. Consolidare queste indicazioni per una specifica tipologia di dispositivo permette di redigere un documento di alto valore scientifico, capace di guidare il professionista nella pratica quotidiana. La sintesi che segue è stata elaborata utilizzando Gemini 3 Flash (Paid Tier), analizzando le evidenze più recenti in risposta al seguente quesito: “Quali sono le ultime raccomandazioni internazionali per la gestione della terapia infusionale tramite accesso venoso periferico?”Per saperne di più leggi l'articolo complet...
2026-01-2705 min
InfermieriAttiviLaurea Magistrale Clinica vs Master: quale percorso scegliere nel 2026?L'anno 2026 si delinea come un momento di cambiamento per la professione infermieristica in Italia, segnando il passaggio definitivo da una formazione orientata prevalentemente al management e alla didattica verso un modello di specializzazione clinica avanzata.La crisi di attrattività che ha colpito la professione, manifestatasi con un calo senza precedenti delle immatricolazioni e una carenza strutturale di personale stimata in decine di migliaia di unità, ha spinto il Ministero dell'Università e della Ricerca (MUR) e il Ministero della Salute a una riforma radicale dei percorsi formativi post-base.Per saperne di più leggi l'articolo completo su InfermieriAttivi: "Laur...
2026-01-2305 min
InfermieriAttiviUn'analisi critica ed evolutiva dell'Evidence-Based Practice per la dirigenza e la clinica infermieristicaNel panorama sanitario contemporaneo, la professione infermieristica si trova a navigare in un ecosistema di complessità crescente, caratterizzato da una rapida obsolescenza delle conoscenze biomediche, da vincoli economici sempre più stringenti e da una domanda di salute che richiede risposte non solo tecnicamente ineccepibili, ma anche eticamente sostenibili e profondamente umanizzate.Per l'infermiere esperto, che opera all'intersezione tra la clinica avanzata, la formazione e la gestione dei processi assistenziali, la transizione dal paradigma tradizionale — fondato sull'autorità, sull'intuizione non verificata e sulla fisiopatologia teorica — verso un paradigma fondato sulle prove empiriche rappresenta non una mera evoluzione metodologica, ma una vera e propr...
2026-01-2306 min
InfermieriAttiviCalcolosi della colecisti e assistenza integrata al paziente sottoposto a colecistectomiaNei paesi occidentali, la prevalenza di questa condizione interessa una quota significativa della popolazione adulta, con una distribuzione che tende ad aumentare progressivamente con l'avanzare dell'età.La gestione del paziente affetto da calcolosi biliare ha subito, negli ultimi decenni, una trasformazione radicale, evolvendo da un approccio puramente interventista verso un modello di cura multidisciplinare che integra tecniche chirurgiche mini-invasive, protocolli di recupero accelerato (ERAS) e una pianificazione assistenziale basata sull'evidenza scientifica e sull'utilizzo di linguaggi standardizzati.Per saperne di più leggi l'articolo completo su InfermieriAttivi: "Calcolosi della colecisti e assistenza integrata al paziente sottoposto a colecistectomia: analisi cl...
2026-01-1905 min
InfermieriAttiviIl costo del lavoro di un infermiere a seconda della fruizione di ferie e permessiQuesto articolo nasce da una curiosità, quanto cambia per l'azienda ASL il costo di un infermiere se non facesse le ferie, mentre se le fa tutte oppure se le facesse tutte e anche dei giorni di congedo? Il CCNL Sanità prevede tanti giorni di permesso e ferie ma qualcuno è mai riuscito/a a farli davvero tutti? Io credo che il motivo sia il variare del costo orario che si determina e per questo ho realizzato un prompt per Gemini pro e il risultato è stato molto interessante.Per saperne di più leggi l'articolo completo su InfermieriAttivi: "Il costo del lavor...
2026-01-1205 min
InfermieriAttiviLa gestione clinica del rischio nella Risonanza MagneticaLa Risonanza Magnetica (RM) è una delle più potenti e versatili tecniche di imaging diagnostico a disposizione della medicina moderna. A differenza della Tomografia Computerizzata o della Radiologia convenzionale, la RM non utilizza radiazioni ionizzanti. Tuttavia, essa si basa sull'interazione del corpo umano con campi magnetici estremamente intensi e dinamici, che introducono rischi fisici, elettromagnetici e termici distinti e complessi. Proprio per questo motivo ho voluto fare una ricerca con Gemini Pro per indigare sulla sicurezza della RM che non può quindi essere data per scontata e richiede protocolli rigorosi e una profonda comprensione dei principi fisici sottostanti.Per sap...
2026-01-1211 min
InfermieriAttiviUn'analisi comparata delle teoriche Infermieristiche e dei modelli concettualiL'evoluzione dell'infermieristica da vocazione caritatevole, spesso subordinata a ordini religiosi o militari, a disciplina scientifica autonoma e accademica rappresenta uno dei percorsi intellettuali più complessi e affascinanti della storia della medicina moderna.Questa transizione non è stata meramente organizzativa o tecnica, ma profondamente epistemologica. Ha richiesto la definizione di un corpo di conoscenze proprio, distinto dalla medicina curativa (che si occupa della diagnosi e del trattamento della patologia) e focalizzato invece sulla risposta umana ai problemi di salute reali o potenziali.Per saperne di più leggi l'articolo completo su InfermieriAttivi: "Un'analisi comparata delle teoriche Infermieristiche e dei modelli con...
2026-01-0906 min
InfermieriAttiviProteggere il paziente, preservare il futuro: il contributo infermieristico alla lotta contro l'antibiotico resistenzaNel panorama sanitario contemporaneo, poche sfide si presentano con la complessità e l'urgenza dell'antibiotico-resistenza (AMR, Antimicrobial Resistance). Definita dalle principali agenzie sanitarie mondiali come una "pandemia silenziosa", l'AMR non rappresenta meramente una problematica clinica circoscritta ai reparti di malattie infettive, ma costituisce una minaccia sistemica.L'era post-antibiotica, un tempo scenario distopico ipotizzato dalla letteratura scientifica, sta assumendo contorni sempre più tangibili, con proiezioni epidemiologiche che stimano, in assenza di interventi correttivi radicali, come l'AMR possa divenire la prima causa di mortalità globale entro il 2050, superando patologie oncologiche e cardiovascolari.Per saperne di più leggi l'articolo completo su I...
2026-01-0606 min
InfermieriAttiviL'evoluzione della professione infermieristica in Italia: analisi storica, normativa e istituzionale (1925–2025)L'evoluzione della figura infermieristica in Italia costituisce uno dei capitoli più complessi e affascinanti della storia sociale e sanitaria del Paese.Analizzare questo percorso significa attraversare un secolo di trasformazioni radicali che hanno investito non solo le tecniche di cura, ma la concezione stessa della salute, il ruolo della donna nella società, l'architettura accademica e la giurisprudenza. Per saperne di più leggi l'articolo completo su InfermieriAttivi: "L'evoluzione della professione infermieristica in Italia: analisi storica, normativa e istituzionale (1925–2025)"Deep Dive realizzato con l'IA Gemini Pro.
2026-01-0506 min
InfermieriAttiviIl funzionario infermiere e la governance dell'invalidità civile: trattato per la preparazione al concorso INPSL'evoluzione del sistema di welfare italiano, sotto la spinta di pressioni demografiche epocali e di vincoli di bilancio sempre più stringenti, ha determinato una profonda ridefinizione delle figure professionali operanti all'interno della Pubblica Amministrazione.In questo scenario, l'Istituto Nazionale della Previdenza Sociale (INPS) rappresenta l'architrave su cui poggia la sicurezza sociale del Paese.Per l'infermiere esperto che ambisce a entrare nei ruoli dell'Istituto, comprendere la natura di questa trasformazione è il primo, ineludibile passo verso il successo concorsuale.Per saperne di più leggi l'articolo completo su InfermieriAttivi: "Il funzionario infermiere e la governance dell'invalidità civile: trattato per la p...
2026-01-0505 min
InfermieriAttiviDimissioni e ferie residue: guida completa alla donazione delle ferie solidali nel nuovo Ccnl sanitàAnalisi dettagliata dell'articolo 38 del contratto 2022-2024: procedure, calcolo dei giorni cedibili e le nuove tutele per non perdere il diritto alla monetizzazione in caso di dimissioni.Quando un infermiere decide di rassegnare le dimissioni dal Servizio sanitario nazionale, si trova spesso a dover gestire un accumulo significativo di ferie non godute e ore di riposo arretrate. In un contesto lavorativo segnato dalla carenza di organico, smaltire questo "tesoretto" durante il periodo di preavviso è spesso impossibile.Se da un lato la giurisprudenza europea ha recentemente rafforzato il diritto al pagamento delle ferie (monetizzazione), dall'altro l'istituto delle f...
2026-01-0205 min
InfermieriAttiviLa gestione del debito formativo ECM nella professione infermieristicaL'Educazione Continua in Medicina (ECM) rappresenta, nell'ordinamento sanitario italiano, non un mero adempimento burocratico, bensì il pilastro su cui si erige la garanzia della qualità delle cure e la sicurezza del paziente. Per la professione infermieristica, l'aggiornamento continuo è elevato a dovere deontologico e obbligo di legge, radicato nell'articolo 16-bis del Decreto Legislativo n. 502 del 1992 e successive modificazioni, che ha istituito il sistema di formazione continua.Nel corso dell'ultimo ventennio, il sistema ha subito una metamorfosi sostanziale, transitando da un modello rigido e centralizzato a uno flessibile, basato sulla responsabilità individuale del professionista e sulla misu...
2026-01-0205 min
InfermieriAttiviLa crisi sistemica del Pronto Soccorso in Italia: analisi delle criticità, impatti strutturali e percorsi di riformaIl Pronto Soccorso (PS) rappresenta l'interfaccia più critica e visibile del Sistema Sanitario Nazionale (SSN) italiano, garantendo l'universalità di accesso alle cure urgenti. La prolungata condizione di stress operativo, spesso definita crisi, che affligge le Unità di PS su scala nazionale, non è un fenomeno contingente, ma il sintomo di disfunzioni strutturali e carenze accumulate nel corso degli ultimi decenni.La resilienza del sistema emergenza-urgenza è stata messa a dura prova, evidenziando inadeguatezze strutturali e di dotazione organica che non sono più al passo con le crescenti esigenze demografiche e cliniche.Leggi l'articolo completo su InfermieriAttivi: "La crisi sistemica del Pr...
2025-12-0405 min
InfermieriAttiviEcosistema contrattuale infermieristico in Italia: analisi comparata dei CCNL, dinamiche retributive e istituti di welfareIl tempo di lavoro, all'interno del complesso ecosistema sanitario italiano, trascende la mera definizione contrattuale di prestazione d'opera in cambio di retribuzione.Esso costituisce la variabile fondamentale attraverso cui si garantisce la continuità assistenziale, principio cardine sancito implicitamente dall'articolo 32 della Costituzione Italiana e reso operativo dai Livelli Essenziali di Assistenza (LEA).La gestione delle risorse umane infermieristiche, in particolare, si trova oggi al crocevia tra rigidi vincoli di bilancio, normative europee sulla sicurezza psicofisica del lavoratore e una carenza strutturale di organico che impone l'utilizzo intensivo di istituti di flessibilità oraria.Leggi l'articolo completo su...
2025-12-0305 min
InfermieriAttiviLa gestione della dieta vegana in età pediatrica: una revisione critica e pratica basata sulle evidenzeLa scelta di aderire a un regime alimentare vegetariano o vegano è in costante aumento in Italia e a livello globale.Le organizzazioni sanitarie e nutrizionali sottolineano i benefici che un consumo regolare di alimenti di origine vegetale può apportare alla salute e alla prevenzione di alcune patologie. Tuttavia, in età evolutiva, la restrizione alimentare richiede una gestione clinica meticolosa. È fondamentale distinguere tra le diverse tipologie di dieta vegetariana: la Dieta Latteo-Ovo-Vegetariana (LOV) esclude carne e pesce, ma include latticini e uova; la Dieta Vegana (VEG) esclude totalmente tutti i prodotti di origine animale, compresi latticini, uova e miele.
2025-12-0205 min
InfermieriAttiviLa mobilità infermieristica transnazionale: regolamentazione, equivalenze accademiche e geopolitica delle professioni sanitarieLa professione infermieristica, nel terzo decennio del XXI secolo, si configura non più come una pratica confinata ai perimetri nazionali, bensì come una risorsa critica all'interno di un mercato del lavoro sanitario globalizzato e interconnesso.La carenza strutturale di personale sanitario, esacerbata dalle dinamiche demografiche di invecchiamento della popolazione nei paesi OCSE e dalle conseguenze a lungo termine della pandemia globale, ha trasformato la mobilità internazionale degli infermieri da un fenomeno episodico a una componente strutturale delle politiche sanitarie nazionali.Leggi l'articolo completo su InfermieriAttivi: "La mobilità infermieristica transnazionale: regolamentazione, equivalenze accademiche e geopolitica delle professioni sanitarie"....
2025-11-2305 min
InfermieriAttiviOPI e sindacati: guida alle differenze per infermieri, normativa e funzioniIl panorama sanitario italiano è caratterizzato da una complessità istituzionale che spesso disorienta il professionista, in particolare l'infermiere, il quale si trova a operare all'intersezione di molteplici sfere di influenza normativa, etica e contrattuale. Una delle ambiguità più persistenti e dannose, che pervade tanto il dibattito accademico quanto le discussioni di corsia, riguarda la sovrapposizione concettuale tra l'Ordine delle Professioni Infermieristiche (OPI) e le Organizzazioni Sindacali.Puoi leggere l'articolo completo su InfermieriAttivi dal titolo: "OPI e sindacati: guida alle differenze per infermieri, normativa e funzioni".Deep Dive realizzato con l'IA Gemini Pro.
2025-11-2306 min
InfermieriAttiviStipendi Infermieri 2025: Italia vs Europa e potere d'acquisto realeL'Europa si trova oggi ad affrontare quella che l'Organizzazione Mondiale della Sanità (OMS) e l'OCSE hanno definito una "doppia minaccia" per la sostenibilità dei sistemi sanitari: la convergenza tra un rapido invecchiamento della popolazione generale, che incrementa la domanda di cure complesse e croniche, e l'invecchiamento della stessa forza lavoro sanitaria, che riduce l'offerta di professionisti attivi.1Non si tratta di una semplice carenza numerica, ma di una crisi strutturale che sta ridefinendo le dinamiche del mercato del lavoro sanitario continentale.Leggi l'artioclo completo su InfermieriAttivi: "Stipendi Infermieri 2025: Italia vs Europa e potere d'acquisto reale".De...
2025-11-2106 min
InfermieriAttiviLavorare in Irlanda, analisi tecnica e procedurale per l'inserimento professionale del personale infermieristicoIl rapporto fornisce una guida tecnica completa per l'Infermiere italiano che mira a lavorare in Irlanda come Staff Nurse.L'analisi dettagliata spiega il processo di accreditamento gestito dal NMBI (Nursing and Midwifery Board of Ireland), con un focus sulla categoria Gruppo 1 (G1) per il riconoscimento automatico della laurea italiana.Vengono esaminati i requisiti linguistici (IELTS/OET) e le recenti modifiche che hanno abbassato il punteggio minimo di Writing.L'articolo chiarisce l'ingegneria documentale (CCPS, Attestato di Conformità Ministero della Salute) e analizza i pacchetti Relocation HSE (fino a €4,160) e le cruciali clausole di Clawback. Infine, affronta la principale sfi...
2025-11-2006 min
InfermieriAttiviClassificazione e gestione delle Lesioni da Pressione (LDP)Le Lesioni da Pressione (LdP), note storicamente come piaghe da decubito, rappresentano una delle complicanze più rilevanti e onerose nella gestione dei pazienti con mobilità ridotta, in particolare all'interno della popolazione anziana e cronica. La gestione e la prevenzione delle LdP costituiscono una responsabilità assistenziale primaria dell'infermiere, rendendo indispensabile un costante approfondimento delle competenze in materia.Sabrina, una lettrice di InfermieriAttivi mi ha chiesto di elaborare un report focalizzato sulla classificazione e sulle strategie di gestione delle LdP. Tuttavia, è fondamentale riconoscere che, nonostante l'importanza delle linee guida pratiche, la conoscenza scientifica sulle cause profonde dell'insorgenza delle LdP presenta ancora l...
2025-11-1906 min
InfermieriAttiviIl ruolo dell'infermiere nella telemedicina: un'analisi basata sull'evidenza di PubMedLa rapida evoluzione delle tecnologie di comunicazione e informazione (ICT) ha portato a una trasformazione radicale nel panorama della sanità.La telemedicina, un tempo considerata una soluzione di nicchia, è ora riconosciuta come una strategia essenziale per garantire la continuità assistenziale, in particolare per la gestione delle patologie croniche e l'assistenza nelle aree territoriali e remote.All'interno di questo contesto digitale, il ruolo dell'infermiere, attraverso il telenursing o la teleassistenza, si è dimostrato non solo cruciale, ma fondamentale per l'efficacia e la sostenibilità dei servizi sanitari remoti.Leggi l'articolo completo su InfermieriAttivi: "Il ruolo dell'infermiere nella telemedicina: un'analisi basata sull'evidenza di Pu...
2025-11-1308 min
InfermieriAttiviL'infermiere e gli elementi sugli adempimenti medico-legali di competenza dell’INPSL'INPS ha un intensa attività con adempimenti medico-legali e di conseguenza l'infermiere funzionatio ne è parte integrante del processo. Questo elaborato nasce per aggiungere delle informazioni utili per il concorso dell'INPS per 138 infermieri. L'elaborato è stato realizzato con Gemini pro 2.5 e si articola con 3 domande: Mi fai un elenco degli elementi sugli adempimenti medico-legali di competenza dell’INPS.Qual è l'attività e il ruolo dell'infermiere sugli adempimenti medico-legali di competenza dell’INPS.Crea 30 domande sugli adempimenti medico legali dell'INPS, per un concorso da infermiere all'INPS, le domande devono essere a risposta multipla, con 4 soluzioni di cui una sola esatta e ad ogni domanda spi...
2025-11-1207 min
InfermieriAttiviCCNL Sanità per infermieri arretrati da 980 a 1600 euroGli arretrati per la maggior parte degli infermieri saranno compresi dai 980 euro ai 1600 per i neoassunti, poi ci sono variazioni a seconda se si ha un partime o se si è assunti da pochi mesi.La differenza è sostanziale dato che il neoassunto avrà un importo più alto e il calcolo è semplice. L'importo più alto resta quello degli infermieri di PS, che hanno un conteggio a parte.Leggi l'articolo completo su InfermieriAttivi: "CCNL Sanità per infermieri arretrati da 980 a 1600 euro".Deep Dive realizzato con l'IA Gemini Pro.
2025-11-1108 min
InfermieriAttiviProiezione a 10 anni sulle iscrizioni a infermieristica: analisi strutturale dell'impatto del calo demografico e dell'attrattività professioQuesta proiezione è implacabile ed evidenzia come i problemi per gli infermieri non siano finiti ma sono solo all'inizio. Il report è stato realizzata grazie al rapporto "CORSI DI LAUREA DELLE PROFESSIONI SANITARIE Dati sull’accesso ai Corsi e programmazione dei posti nell’ A.A. 2025-26" di Angelo Mastrillo*, Lorenzo Bevacqua e Elisabetta Cenerelli ed integrato con i dati pubblicati online.L'analisi è realizzata con il "mio" Gemini che riceve ogni giorno domande di infermieristica e in questo caso gli ho chiesto: Il report consente di estrapolare una proiezione per i prossimi 10 anni su come andranno le iscrizioni ad infermieristica, tenendo presente anche l...
2025-11-0908 min
InfermieriAttiviCome gestire i crediti ECM del triennio, in 5 mosseIl triennio formativo è ormai alle battute finali e, dopo 25 anni dall'introduzione dell'obbligo di Educazione Continua in Medicina (ECM), il sistema di verifica è diventato sempre più rigoroso. È fondamentale che ogni professionista, sia dipendente, sia libero professionista, sia chi lavora all'estero ma mantiene l'iscrizione in Italia, sia pienamente consapevole della propria posizione. Il controllo dei crediti è meticoloso. In particolare, gli Ordini Provinciali (OPI) esercitano una sorveglianza stringente:Infermieri all'estero: La mancata acquisizione dei crediti ECM può portare alla decadenza dell'iscrizione all'Albo, precludendo il diritto di esercitare in Italia.Liberi professionisti: Sono soggetti alla responsabilità diretta degli OPI e risch...
2025-11-0608 min
InfermieriAttiviArretrati per infermieri e OSS di PS, stimati 5000-6000 euroNel CCNL Sanità 2022-2024, chi beneficerà dell'Indennità di Pronto Soccorso?Abbiamo calcolato l'importo lordo mensile per gli infermieri e le altre figure di PS, scoprendo, con sorpresa (e in accordo con alcune stime sindacali), che le cifre definitive sono notevolmente più alte rispetto alle previsioni inizialiLa risposta che mi ha fornito Gemini è molto dettagliata gli importi sono simili a quelli che ha stimato ChatGPT con la stessa domanda. Ovviamente visto che è un analisi tecnica è sempre possibile che ci siano delle allucinazioni dell'IA, vedi l'articolo, ma ti lascio al report.Leggi l'articolo completo su InfermieriAttivi: "Arretrati per infermieri e OSS di PS...
2025-11-0607 min
InfermieriAttiviIl dilemma del gergo: navigare tra coesione di gruppo e rischio operativo negli ambienti di lavoro specializzatiIn numerosi ambienti di lavoro ad alta specializzazione, si assiste a un fenomeno linguistico tanto diffuso quanto sottovalutato: la progressiva sostituzione del linguaggio tecnico-scientifico, caratterizzato da precisione e univocità, con un linguaggio gergale, quotidiano o volutamente superficiale.Questo processo, che può essere definito come detecnicizzazione o semplificazione colloquiale, non rappresenta una semplice "traduzione" del lessico specialistico per non addetti ai lavori, ma una vera e propria alterazione del codice comunicativo all'interno del gruppo di specialisti stessi.Si tratta di una deriva che si manifesta lungo un continuum: da un lato, una comprensibile ricerca di economia linguistica e di immediatezza; dall'altro, un...
2025-11-0108 min
InfermieriAttiviCCNL Sanità 2022-2024: analisi degli aumenti reali per Infermieri e OSSIl rinnovo del Contratto Collettivo Nazionale di Lavoro (CCNL) del comparto Sanità per il triennio 2022-2024 ha introdotto una serie di modifiche economiche che incidono direttamente sulla busta paga di oltre 580.000 professionisti.Tuttavia, per comprendere l'impatto reale di tali cambiamenti, è necessario andare oltre le cifre medie comunicate e analizzare nel dettaglio come gli aumenti si traducono per figure chiave come l'Infermiere e l'Operatore Socio-Sanitario (OSS), distinguendo tra chi opera su turni e chi svolge un orario giornaliero.Leggi l'articolo completo su InfermieriAttivi: "CCNL Sanità 2022-2024: analisi degli aumenti reali per Infermieri e OSS".Deep Div...
2025-10-2808 min
InfermieriAttiviAnalisi della migrazione infermieristica in Italia e impatto sul Servizio Sanitario NazionaleIl presente rapporto analizza il fenomeno a due vie della migrazione infermieristica che interessa l'Italia, delineando un bilancio complesso e critico per il futuro del Servizio Sanitario Nazionale (SSN).L'analisi rivela una situazione di complessità che richiede una pianificazione pluriennale: l'Italia, che investe risorse significative nella formazione di infermieri altamente qualificati, agisce come un esportatore netto di talento verso sistemi sanitari più attrattivi, diventando al contempo sempre più dipendente dall'importazione di professionisti stranieri per colmare le voragini di organico.L'articolo completo è disponibile su InfermieriAttivi: "Analisi della migrazione infermieristica in Italia e impatto sul Servizio Sanitario Nazionale".
2025-10-2507 min
InfermieriAttiviLa convergenza tra EBM e algoritmo: il futuro presenteL'intersezione tra la pratica medica e l'innovazione tecnologica ha raggiunto un punto di svolta. L'avvento di potenti strumenti di intelligenza artificiale (IA), in particolare i Modelli Linguistici di Grandi Dimensioni (LLM), sta rimodellando le fondamenta stesse di come la conoscenza medica viene acquisita, valutata e applicata.Come infermieri non possiamo ignorare che il cambiamento in arrivo è al pari di quel cambiamento che 25 anni fa rappresentò l'esordio dell'EBM in questi anni ci sarà chi subisce il cambiamento e chi lo governerà.Leggi l'articolo completo con il report esteso scaricabile su InfermieriAttivi: "La convergenza tra EBM e algoritmo: il futu...
2025-10-1408 min
InfermieriAttiviPsoriasi ungueale: molto più che un inestetismoLa psoriasi ungueale, o onicopatia psoriasica, è una malattia che colpisce le unghie e che spesso viene sottovalutata, ma che in realtà è una delle manifestazioni più comuni della psoriasi.La psoriasi è una patologia infiammatoria cronica, multisistemica e polimorfa, che si manifesta principalmente con lesioni eritemato-desquamative sulla pelle. L'importanza clinica della psoriasi ungueale è, in realtà, notevole. Non solo compromette la funzionalità e la qualità della vita dei pazienti a causa del dolore e della fragilità delle unghie, ma può anche rappresentare la prima o addirittura l'unica espressione della malattia, rendendo la sua identificazione cruciale per una diagnosi precoce. La sua gestione, pertanto, richiede un...
2025-09-3005 min
InfermieriAttiviL'infermiere tutor: formare gli infermieri di domaniL'attuale panorama sanitario, caratterizzato da una crescente complessità assistenziale e da rapidi progressi tecnologici e clinici, impone la formazione di professionisti infermieri dotati non solo di solide competenze tecniche, ma anche di pensiero critico, autonomia decisionale e una radicata identità professionale.In risposta a questa esigenza, la formazione universitaria infermieristica ha progressivamente abbandonato un modello basato sul mero addestramento per abbracciare un paradigma fondato sull'apprendimento dall'esperienza, in cui il tirocinio clinico assume un ruolo centrale e qualificante.In questo contesto, emerge con forza la figura dell'infermiere tutor, un professionista esperto che agisce come perno strategico del processo formativo, un...
2025-09-3007 min
InfermieriAttiviLo stress lavoro-correlato nella professione infermieristica: manifestazioni fisiche, comportamentali e percorsi di supportoLo stress lavoro-correlato e la sua conseguenza più grave, la sindrome da burnout, rappresentano un "fenomeno occupazionale" ufficialmente riconosciuto dall'Organizzazione Mondiale della Sanità. Le professioni d'aiuto (helping professions), e in particolare quella infermieristica, sono esposte a un rischio eccezionalmente elevato.Gli infermieri sono gravati da una duplice fonte di stress: quella personale, comune a ogni individuo, e quella intrinseca al ruolo, legata alle complesse esigenze fisiche ed emotive della persona assistita.Questo carico costante logora le risorse psicofisiche, portando a una condizione di esaurimento. Il contesto attuale aggrava ulteriormente questa vulnerabilità: il sistema sanitario, afflitto da una...
2025-09-2008 min
InfermieriAttiviZoccoli infermieri, nuovi e vecchi modelliGli zoccoli sanitari rappresentano una delle calzature più diffuse tra il personale infermieristico e sanitario. Sebbene la traspirabilità, che mantiene il piede più fresco rispetto a una scarpa completamente chiusa, sia un vantaggio apprezzato, la loro popolarità deriva da un insieme di fattori che includono comfort, praticità e igiene.Per orientarsi nella scelta, è utile suddividere i modelli in base al materiale di costruzione, che ne determina le caratteristiche fondamentali. Poiché la maggior parte degli zoccoli professionali è realizzata in un monoblocco, il materiale diventa il primo e più importante criterio di valutazione.Polimeri termoplastici (come SEBS o PU): Questi mat...
2025-09-1509 min
InfermieriAttiviL'orizzonte pensionistico in movimento: analisi prospettica e strategie per l'infermiere del SSNPianificare il proprio futuro pensionistico oggi significa navigare in un sistema complesso e, soprattutto, dinamico.A differenza di un percorso a tappe fisse, la normativa previdenziale italiana è soggetta a un meccanismo di adeguamento automatico che lega i requisiti per l'accesso alla pensione all'evoluzione della speranza di vita della popolazione. Questo meccanismo, gestito su base biennale, ha lo scopo di garantire la sostenibilità a lungo termine del sistema a fronte dell'allungamento della vita media.Leggi l'articolo completo realizzato con Gemini su InfermieriAttivi "L'orizzonte pensionistico in movimento: analisi prospettica e strategie per l'infermiere del SSN".
2025-09-0507 min
InfermieriAttiviLa musicoterapia nella sanità: un'analisi sulle applicazioni cliniche e il ruolo collaborativo dell'infermiereLa musicoterapia rappresenta un approccio clinico sistematico che utilizza esperienze musicali e le loro espressioni, come il suono, il corpo e la voce, per perseguire obiettivi terapeutici, preventivi o riabilitativi.A differenza di un semplice ascolto musicale a scopo di intrattenimento, il suo fine ultimo è quello di sviluppare le funzioni potenziali e/o residue dell'individuo, facilitando una migliore integrazione intra- e interpersonale e, di conseguenza, migliorando la qualità della vita. Questa disciplina si fonda su principi operativi distinti, tra cui la partecipazione attiva del paziente, la centralità di un rapporto di fiducia e di accettazione incondizionata, l'adattamento personalizzato della tec...
2025-09-0408 min
InfermieriAttiviLoop-X: un'analisi approfondita del robot di imaging intraoperatorio e del suo impatto sul flusso di lavoro chirurgicoL'evoluzione della pratica chirurgica moderna è caratterizzata da una transizione fondamentale: dal fare affidamento quasi esclusivo sull'imaging pre-operatorio alla crescente domanda di dati in tempo reale, acquisiti direttamente durante l'intervento. Questa esigenza di informazioni immediate e precise ha catalizzato lo sviluppo di tecnologie di imaging intraoperatorio sempre più sofisticate.In questo panorama, il sistema Loop-X di Brainlab emerge non come un semplice miglioramento incrementale della tecnologia di Tomografia Computerizzata (TC) portatile, ma come un robot di imaging mobile che rappresenta un cambio di paradigma, integrando robotica avanzata, capacità di imaging di alta gamma e connettività dei dati.1Legg...
2025-09-0407 min
InfermieriAttiviGuida completa alla legge 104/92: diritti e tutele per lavoratori e caregiver nel settore pubblico e privatoLa Legge-quadro n. 104 del 5 febbraio 1992 rappresenta una delle normative cardine dell'ordinamento italiano, istituita per garantire l'assistenza, l'integrazione sociale e la tutela dei diritti delle persone con disabilità.1Il suo scopo non è meramente assistenziale, ma profondamente inclusivo: la legge mira a promuovere il pieno rispetto della dignità umana, l'autonomia e la completa integrazione della persona con disabilità nella famiglia, nella scuola, nel mondo del lavoro e nella società in generale.2I suoi principi si fondano sulla rimozione attiva delle condizioni invalidanti e degli ostacoli, fisici e culturali, che possono generare stati di emarginazione o esclusione sociale, assicurando così la piena partec...
2025-09-0109 min